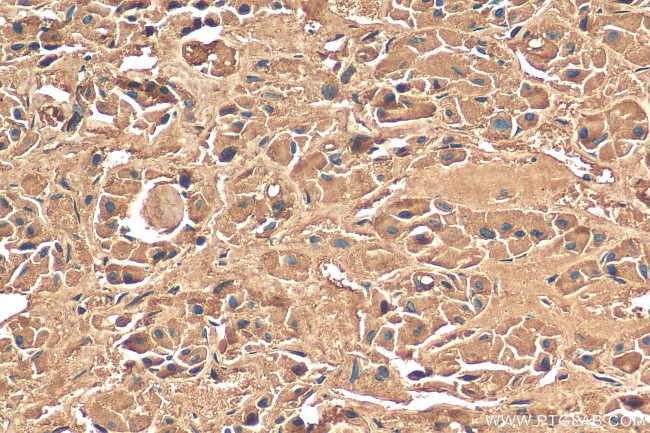
POMC Antibody in Immunohistochemistry (Paraffin) (IHC (P))

Search
Proteintech
POMC Polyclonal Antibody
{{$productOrderCtrl.translations['antibody.pdp.commerceCard.promotion.promotions']}}
{{$productOrderCtrl.translations['antibody.pdp.commerceCard.promotion.viewpromo']}}
{{$productOrderCtrl.translations['antibody.pdp.commerceCard.promotion.promocode']}}: {{promo.promoCode}} {{promo.promoTitle}} {{promo.promoDescription}}. {{$productOrderCtrl.translations['antibody.pdp.commerceCard.promotion.learnmore']}}
产品信息
22102-1-AP
种属反应
宿主/亚型
分类
类型
抗原
偶联物
形式
浓度
规格
纯化类型
保存液
内含物
保存条件
运输条件
产品详细信息
Immunogen sequence: WCLESSQCQD LTTESNLLEC IRACKPDLSA ETPMFPGNGD EQPLTENPRK YVMGHFRWDR FGRRNSSSSG SSGAGQKRED VSAGEDCGPL PEGGPEPRSD GAKPGPREGK RSYSMEHFRW GKPVGKKRRP VKVYPNGAED ESAEAFPLEF
靶标信息
This gene encodes a polypeptide hormone precursor that undergoes extensive, tissue-specific, post-translational processing via cleavage by subtilisin-like enzymes known as prohormone convertases. There are eight potential cleavage sites within the polypeptide precursor and, depending on tissue type and the available convertases, processing may yield as many as ten biologically active peptides involved in diverse cellular functions. The encoded protein is synthesized mainly in corticotroph cells of the anterior pituitary where four cleavage sites are used; adrenocorticotrophin, essential for normal steroidogenesis and the maintenance of normal adrenal weight, and lipotropin beta are the major end products. In other tissues, including the hypothalamus, placenta, and epithelium, all cleavage sites may be used, giving rise to peptides with roles in pain and energy homeostasis, melanocyte stimulation, and immune modulation. These include several distinct melanotropins, lipotropins, and endorphins that are contained within the adrenocorticotrophin and beta-lipotropin peptides. Mutations in this gene have been associated with early onset obesity, adrenal insufficiency, and red hair pigmentation. Alternatively spliced transcript variants encoding the same protein have been described.
仅用于科研。不用于诊断过程。未经明确授权不得转售。
篇参考文献 (0)
生物信息学
蛋白别名: adrenal corticotropic hormone; adrenocorticotropic hormone; adrenocorticotropin; alpha-melanocyte stimulating hormone; alpha-melanocyte-stimulating hormone; alpha-MSH; beta-endorphin; beta-LPH; beta-melanocyte-stimulating hormone; beta-MSH; corticotropin-like intermediary peptide; Corticotropin-lipotropin; gamma-LPH; gamma-MSH; lipotr; lipotropin beta; lipotropin gamma; melanotropin alpha; melanotropin beta; melanotropin gamma; met-enkephalin; opiomelanocortin prepropeptide; OTTHUMP00000119991; OTTHUMP00000200964; POMC; Precursor of MSH; pro-ACTH-endorphin; Pro-opiomelanocortin; proopiomelanocortin precursor; proopiomelanocortin preproprotein
基因别名: ACTH; alpha-MSH; alphaMSH; BE; Beta-LPH; beta-MSH; CLIP; Gamma-LPH; gamma-MSH; LPH; MSH; NPP; OBAIRH; POC; POMC; Pomc-1; Pomc1
UniProt ID: (Human) P01189, (Mouse) P01193
Entrez Gene ID: (Human) 5443, (Mouse) 18976